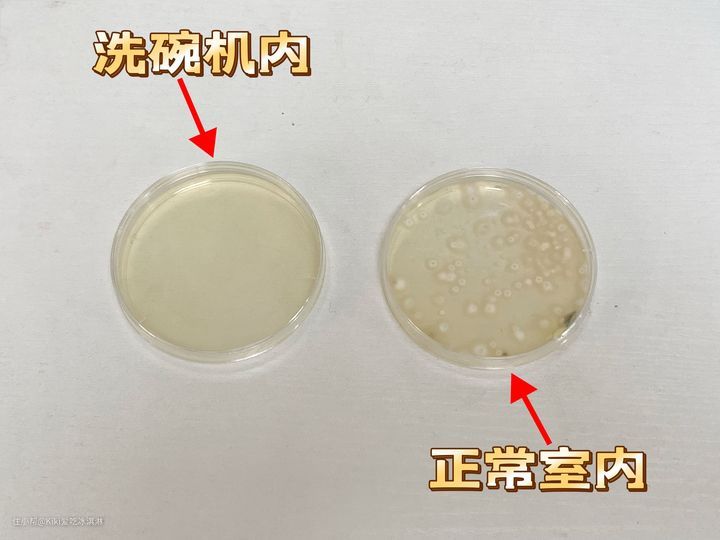

亿田蒸烤独立集成灶、集成水槽洗碗机实测测评
Kiki爱吃冰淇淋
2023-12-22
KIKI作为一个喜欢烹饪的厨盲,做菜全靠“黑科技”。细数下来,以前家里摆放的厨电十个手指头都数不过来,包括烟灶、蒸烤箱、空气炸锅、洗碗机、消毒柜等厨电占据了厨房大部分空间。加上厨房空间有限,整个厨房就显得杂乱无章,甚至给人一种压抑感,烹饪体验非常差。搬新家后,我对以前家里的很多厨电都断舍离,决定一步到位把厨房做成集成烹洗中心。
做厨电测评这么长时间,我发现遇到这样问题的朋友不在少数,都是苦于厨房空间小,无法购置体积较大的厨电,难以满足实际需求。像这样的情况,我更推荐大家选择集成厨电套系,不仅节省空间,而且整洁美观时尚,使用起来方便又快捷。比如集合了烟机+灶具+蒸箱+烤箱功能的蒸烤集成灶,还有集成水槽洗碗机,都是一台顶N台的时尚厨电产品。
KIKI之前一直很喜欢亿田家的爆款“集成烹洗中心”,仅需1㎡空间,就可以将集成灶、蒸箱、烤箱、水槽、洗碗机全部囊括,在方寸之地打造真正小而美的现代厨房。
“亿田集成烹洗中心”外观时尚可以适配大部分家居风格、功能丰富、实用便捷,这就是我一直想要打造的集成厨房!路过亿田的集成烹洗中心之后我就挪不开眼了,跟店长沟通后,店长同意我测评它们家的爆款“集成烹洗中心”套装。今天我就来跟大家分享亿田的集成烹洗中心套系产品实测测评,希望给正在装修或要购置厨电的朋友们一些实际的建议。
先给大家看看我自己想要买的亿田集成烹洗中心套装(S8A +XE92P )

蒸烤独立集成灶S8A
- 蒸烤独立集成灶:左蒸右烤、边煮边炒,多种菜式同步烹饪,15分钟就能搞定一桌美味,家人朋友来聚餐再也不用着急忙慌地做菜了。
- 油烟机部分:侧吸下排,拥有20m³/min超强吸力、99.95%油烟吸净率,保障家里没有油烟扩散,下厨更安心。
- 灶具部分:5.0KW极炽燃烧,燃烧热效率高,火力大更适合中式爆炒;黑晶工艺台面,防油、防刮、防指纹,清洁更方便;一级能效,更节能省气又省电。
- 蒸烤箱部分:48L蒸烤+26L烤箱独立运行,同时开启做菜效率更高;蒸箱100℃高温速蒸,健康蒸菜一次搞定;烤箱50-230℃宽温域,多种模式可以做更多样的美食;低脂空气炸,享受更健康的美味。
- 其他设计:可拆卸挡烟板、全金属烟腔更方便日常清洁;蒸烤箱内胆无缝焊接,同样非常好清洁;21cm宽幅置物台,增加收纳空间,做菜时方便拿取调料。
- 安装节省1米地柜费用,还能增加顶部吊柜空间,让厨房空间可以更合理地得到发挥。
集成水槽洗碗机XE92P
- 大双槽配置:大槽空间大可以清洗锅具,小槽有超声波清洁功能,日常清洗果蔬、海鲜更干净。
- 洗碗机12套大容量:720°高压旋洗,70℃高温去油,双臂喷淋无死角冲洗;6大洗涤模式,使用更方便。
- 洗碗机烘干:PTC解热烘干,配置紫外线杀菌、新风换气系统,有效避免餐具二次污染。
- 其他配置:软水装置清洁餐具更干净,还能保护洗碗机不被水垢堵塞;三重过滤系统,高效过滤食物残渣;304不锈钢内胆,更安全、更耐用、更易清洁。

添加图片注释,不超过 140 字(可选)
一、打造集成化厨房有多香?
单独购买的各种厨电,不仅占用台面和橱柜空间,每次使用时要拿取、放置、清洁都非常麻烦。然而集成化厨房让家里的厨电有了更科学的规划和搭配,功能实用又方便,还能提高烹洗效率,同时解放厨房空间。
厨房颜值更高:集成化厨房有统一的设计风格,色系、造型、材质搭配更加时尚大气,整体打造出来的厨房更符合大家的审美。
整体空间更大:集成化厨电有一个很大的特点就是空间规划、功能设计更合理,可以节省珍贵的厨房空间,让烹饪时光更加悠闲美好。
使用体验更好:集成化厨电设计会让厨房行动动线更合理,日常下厨更高效便捷,可以在很大程度上减轻下厨的负担。

二、亿田集成烹洗中心
大家所熟知的亿田旗下产品,可能更多的是市场销售表现非常亮眼的集成灶产品。实际上,亿田在智能厨电领域已经发展了20年,始终坚持创新,保持高质量发展。亿田智能曾在2017年,荣获浙江省人民政府质量奖,是实力与口碑兼具的高端品牌。
近几年,亿田致力于从厨电领域到厨房全场景整体解决方案进阶式发展,希望实现无烟、无害、无人厨房的创新科技迭代升级。“亿田集成烹洗中心”就是其中一项重磅产品。
“亿田集成烹洗中心”套系集成了智能烹洗+鲜蔬餐具洗,打通了食材清洗、蒸烤煎炸各类烹饪、餐后清洁维护等系列环节,将全部功能集于厨房1㎡空间内。在节省厨房使用空间的同时,还提高下厨烹饪效率,让做饭这件事变得更轻松美好。

(一)蒸烤独立集成灶S8A实测
下面我会结合实测,给大家看看亿田集成烹洗中心的实际使用体验到底如何。先来看看蒸烤独立集成灶S8A的参数配置。

1、外观设计+细节展示
蒸烤独立集成灶S8A一直是亿田家的爆款产品。从外观上来看,整体是非常高级有质感的黑色,同时点缀了一些银色,与各种厨房风格都非常适配。

下面给大家看看一些细节部分,包括中间的操作面板,上层的灶具、烟机、烟机上的宽幅台面、可拆卸挡烟板,下层的蒸箱、烤箱、独立水箱等,细节设计都十分考究。



2、AI智能操作面板
下面先来看看它的AI智能操作面板,给大家先演示一下操作界面。
整个操作面板灵敏度非常高,图标显示也清晰明了。如果家里是老人做饭,操作使用也非常简单,很容易就可以学会。
3、烟机效果测试
接下来我打开了双灶和烟机,灶上放置了一个铁锅和一个汤锅,里面都盛满水进行加热。这里我只打开了烟机最小档位,飘起的烟雾很快都被吸进去了。

给大家测一下抽烟风速:

烟机的排风量是20m³/min,比一些中高端品牌的燃气灶排风量还要高。灶台到烟机的距离是28.5cm,可以更高效地排烟。从测试来看,它的排烟效果也非常好,可以快速吸净油烟,不会让油烟进入室内。
4、火力大小展示
亿田S8A燃气灶火力为5.0kW,非常适合中式爆炒,做出各种美味佳肴。

这款是采用了自主研发的燃烧器,大火火力猛;而且是三腔喷射上进风结构,不会出现黄火。调到最大和最小火力,都是蓝焰,而且都非常稳定。 猛火文火自由调节,对于中式厨房来说,不管是爆炒还是慢炖都能完美契合。
5、烤箱功能
这款集成灶的的蒸烤箱是分离式设计,蒸、烤食物可同时进行,节省时间,提高效率。

先来看看烤箱部分,独立烤箱的容量是26L,烤箱容量足够大,不管是烤鱼、烤鸡、烤大蛋糕都绰绰有余。

我用激光测距仪测了烤箱内腔尺寸,大家可以参考一下哈:

烤管配置非常豪华,有上下各三组烤管,再搭配背部热风循环。 启动时,3D循环烤,升温快,而且热量分布均匀,可以保证食材的最佳口感。烤箱共有4种烘焙模式,无论是做肉食,还是西式甜点都非常实用。
6、蒸箱功能
蒸箱的容量更大,有48L,大烤箱容量,不管蒸鱼还是做饭都足够。我们家喜欢吃蒸鱼,人多的时候那种大草鱼一整条,普通蒸箱压根放不进去,亿田这个体积却是足够的。这里我也测量蒸箱的内腔尺寸:

蒸箱部分通过底部加热盘进行加热,温度从38-100℃可调节。这样的宽幅调温,可以在做蒸菜时保持食物的鲜嫩口感,蒸汽均匀穿透食材,美味更加新鲜健康。

7、噪音测试
油烟机里面的风扇高速运转,噪音是不可避免的,一般来说,风量越大,噪音也会越大。下面测试一下整体运行时的噪音情况,这里主要产生噪音的部分还是烟机。测试时,我打开最高档和最低档,分别测试分贝数。

可以看到,烟机运行时最高档的分贝数是64.8dB,最低档分贝数是57.2dB,属于正常在家下厨使用的噪音范围,比普通的烟机噪音更小。与传统分体式烟机相比,分体式油烟机吸油烟口在正上方,与耳朵距离较近,噪音也会更明显,影响使用体验。而集成灶设置侧吸油烟,亿田蒸烤独立系列是下置式风机设计,音源与人耳朵距离较远,噪音更小。
8、清洁测试
厨房此等油烟重地,厨电清洁也是一大麻烦,最后给大家测试一下,使用完之后清洁维护的情况。
灶台采用黑晶工艺台面,防刮、防油、防指纹,非常容易清洁。日常使用之后,用抹布一擦即净,即使有油污也很容清洁干净。 烟机设计了可拆卸的挡烟板,使用一段时间可以拆卸下来用水清洗,十分方便。日常做完菜之后,只需要用抹布擦拭清洁即可。 烤箱内胆采用搪瓷材质,耐高温、耐腐蚀、稳定性高、耐刮花,还非常容易清洁,是非常适合做烤箱内胆的材料。可以看到,这里同样使用抹布擦拭,就可以擦干净油污。 蒸箱内胆是304不锈钢材质,同样也是非常稳定的材质,日常使用也是一擦即净。 另外,蒸烤箱的箱门都是隔热材质,外层是钢化玻璃,不仅可以有效隔热,清洁起来也很方便快捷,有油污的情况下也可以直接用抹布擦拭干净。
(二)集成水槽洗碗机XE92P 实测
接下来是亿田集成水槽洗碗机XE92P测评,大家可以看看它的参数配置。

1、外观设计+细节展示
亿田XE92P采用黑色钢化玻璃工艺,尽显高级。集成洗碗机、水槽、垃圾处理器(选配)、橱柜于一体,简化厨房动线,使用更方便。

这款水槽洗碗机上层配置了一大一小两个水槽,买这款洗碗机还赠送一块木砧板,可以放在水槽上,这块木砧板可以灵活移动,可以在水槽洗菜,砧板上面切菜,避免洗菜后再移动到砧板上切菜的过程中水滴落的问题。

2、触控屏幕
这款水槽洗碗机的操作界面在水龙头下方,设计非常简洁明了。在这个位置操作,可以避免弯腰,而且触控屏幕特别灵敏,手上沾水也能灵敏触控。

3、大水槽测试
下面给大家看一下这个双槽中的大水槽,实测的尺寸是宽39cm、深17.3cm、高43.7cm,整个容量很大,一般家里的铁锅、炖锅都可以放进去。

铁锅放一整个进去都足够:

4、小水槽测试
小水槽的尺寸测量下来是宽23.7cm、深11.2cm、高38.1cm,可以用来清洗蔬菜、水果、海鲜等。大小水槽分开设计,餐具和食物分开洗,更加干净卫生。

小槽搭配超声波清洗功能,可以通过高频震动深度清洁海鲜。经过这种反复的冲击和震荡,可以轻松洗掉食材上的污垢,减轻日常用手清洗的压力,洗的更干净,食用更放心。
5、洗碗机细节
下面给大家看一下洗碗机部分的设计细节。洗碗机容量是12套,日常用餐后的锅碗瓢盆基本都可以容纳进去。

碗篮是上下两层的设计,都可以抽拉出来,搭配了一些组件让餐具更好地摆放进来。大家可以看看碗篮的细节图,可以放入的餐具非常多,而且一般的炒锅也能放进去清洗。

洗碗机的喷淋臂设计为上下双喷淋臂,镰刀型设计,可以把上下堆叠的餐具都清洁干净。高压喷射水流+720°无死角旋转喷洗,即使碗篮内餐具都堆满了也可以无死角清洗。洗碗机内腔采用304不锈钢材质,安全耐用,高温水洗也不会产生异味,稳定性高,而且易于清洁,不会藏污纳垢。
6、洗涤效果测试
下面,我们来测试洗碗机的清洁能力,我在洗碗机内放置了一些脏污的餐具,然后实际测试洗涤效果。

洗涤程序完成后,打开碗篮可以看到餐具全部光洁如新。大家可以从上面的对比图中看到,洗涤效果非常好,所有餐具都清洗干净了,没有留下任何脏污。 洗碗机有6种洗涤模式,这里为了省事,我开启了标准洗模式。洗涤过程中,会采用70℃高温水洗,可以更好地溶解油污,同时还有消毒除菌的功效。
7、烘干效果测试
下面测试一下洗碗机的烘干效果,我直接用刚刚洗好的餐具进行测试。 这款采用了PCT加热烘干的方式,可以快速烘干餐具,减少细菌滋生,避免产生二次污染。
用纸巾擦拭洗涤烘干后的餐具,纸巾上不沾一滴水,烘干后的餐具洁净干爽,避免放置在湿哒哒的环境中细菌滋生。
8、消毒效果测试
洗碗机还自带新风换气系统,并搭配了UV紫外线杀菌功能。接下来,我在洗碗机内腔和正常室内分别放置细菌培养皿,时间是1小时,收集这两处环境中的细菌。然后密封保存带回家用细菌培养箱培养24小时,给大家看看不同环境下细菌的分布情况。
从图上可以看到,放置在洗碗机内腔的培养皿,里面的几乎没有可以看到的细菌。而放在室内空气中的培养皿,有肉眼可见的细菌。所以日常生活中的餐具还是需要经常杀菌消毒,避免空气中的细菌污染餐具。
9、其他配置
洗碗机还有一项软水装置,从水龙头进水后,会先经过软水装置,自动向洗碗机内胆注入软水盐。 洗碗机内采用软水洗涤,可以让餐具更加透亮,而且还能保护洗碗机不被水垢堵塞。 此外,洗碗机还搭配了三重过滤系统,可以有效过滤食物残渣,不让排出的污垢堵塞下水管道。

10、噪音测试
最后给大家看一下刚刚洗涤过程中测试的噪音情况,可以看到洗碗机在运行时的分贝数大约在59dB(这还是我噪音仪紧贴着洗碗机测出来的噪音值,离远一点压根没有这么高),与我们平时聊天说话的音量差不多,不会打扰到家人休息。

三、总结
综合以上分析和测评来看,亿田集成烹洗中心不仅做到了在1㎡空间内集成了烟机、灶具、蒸箱、烤箱、水槽、洗碗机等多种主要厨电,而且每一项的功能都还非常实用、效果非常好。相比其他的独立厨电产品,亿田集成烹洗中心优势非常明显。
- 烟灶性能更强大:20m³/min超强吸力,快速控烟排烟;5.0KW极炽燃烧器,中式爆炒无压力。
- 蒸烤功能更独立:蒸烤箱可独立使用也可同步运行,15分钟快速搞定一桌健康美食。
- 食材清洗更彻底:大水槽清洗空间大,可容纳食材或锅碗多;小水槽超声波清洁,果蔬去农残、海鲜去污,保证食材更干净卫生。
- 洗碗程序更健康:洗、烘、消一体设计,12套大容量无死角清洗,全方位保障餐具干净无污染。
厨房配置这样的集成烹洗中心真的很香,希望这次分享和测评对大家的选购有所帮助。